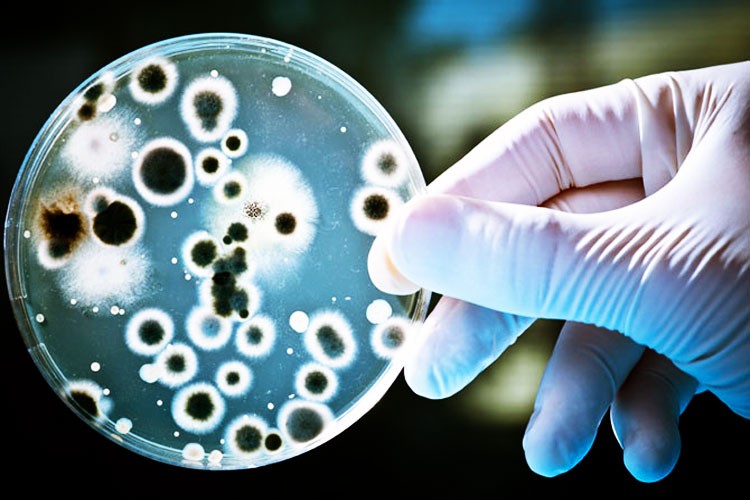
Methylocella silvestris ayudaría contra el calentamiento global

Un estudio muestra que las fugas de gas peligrosas podrían ser combatidas con bacterias, específicamente la bacteria Methylocella silvestris ayudaría contra el calentamiento global.
Las bacterias podrían absorber las fugas de los gases naturales provocados por el hombre antes de ser liberados a la atmósfera y causar el calentamiento global – según una nueva investigación de la Universidad de East Anglia.
Los resultados se publicaron recientemente en la revista Nature que muestra cómo una única cepa bacteriana (Methylocella silvestris) que se encuentran en el suelo y otros entornos en todo el mundo, puede crecer tanto en el metano y el propano que se encuentra en el gas natural.
Originalmente se pensó que la capacidad para metabolizar el metano y otros alcanos gaseosos tales como el propano se llevaría a cabo por diferentes grupos de bacterias. Este nuevo hallazgo es importante porque significa que un tipo de bacterias puede limpiar los componentes del gas natural de manera muy eficiente y reducir la contaminación.
Los hallazgos podrían ayudar a mitigar los efectos de la liberación de gases de efecto invernadero a la atmósfera tanto el gas natural que se filtra en el medio ambiente y los que surgen de la actividad hecha por el hombre, tales como el fracking y los derrames de petróleo.
Los investigadores estudiaron la bacteria Methylocella que se encuentra normalmente en la turba, la tundra y los suelos forestales en el norte de Europa. Este tipo de bacteria también se ha encontrado entre la comunidad microbiana tras el derrame de petróleo de Deepwater Horizon en 2010. Luego midieron su capacidad para crecer en el metano y otros gases.
El investigador principal, el profesor Colin Murrell, de la escuela de Ciencias Ambientales de la Universidad de East Anglia, dijo: «El gas natural de fuentes geológicas contiene metano, así como grandes cantidades de etano, propano y butano.
«Hemos demostrado que un microbio puede crecer tanto en el metano y el propano a una velocidad similar. Esto es debido a que contiene dos sistemas de enzimas fascinantes que utiliza para aprovechar ambos gases a la vez.
«Esto es muy importante para los entornos expuestos a gas natural, ya sea de forma natural o por la actividad humana. Estos microbios pueden desempeñar un papel importante en la mitigación de los efectos del metano y otros gases antes de que tengan la oportunidad de escapar a la atmósfera.
«Estos resultados podrían ser utilizados para informar las decisiones de gestión del uso del suelo. Por ejemplo, las áreas donde se liberan altos niveles de metano y el propano se podrían beneficiar de un ambiente rico en estos microbios, que viven naturalmente en el suelo.
«El metano es un potente gas de efecto invernadero que se libera a partir de fuentes naturales, como los humedales, así como de las actividades humanas, incluyendo la gestión de residuos, las industrias del petróleo y gas, la producción de arroz y la ganadería. A nivel mundial, se estima que más de la mitad de las emisiones del metano son artificiales.
«Molécula-por-molécula, el efecto del metano en el calentamiento global es más de 20 veces mayor que el dióxido de carbono durante un periodo de tiempo 100 años.
Por eso es muy importante que entendamos cómo se puede eliminar biológicamente en el medio ambiente antes de que sea puesto en libertad a la atmósfera».
Lea más: phys.org
¿Qué te parece?